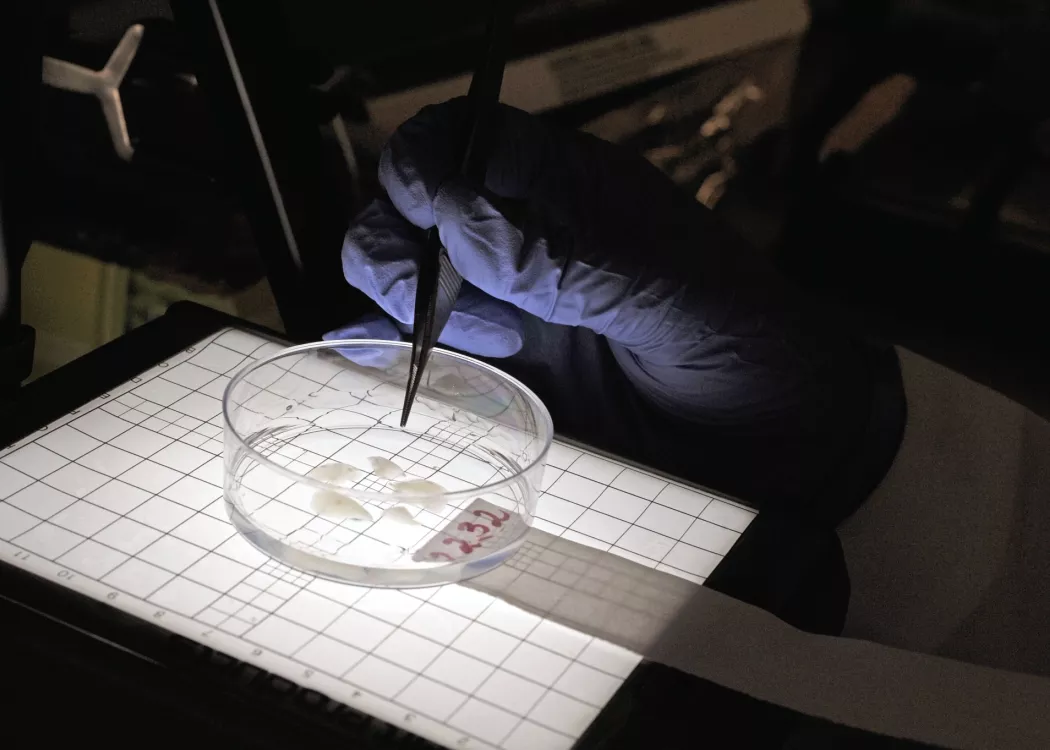

Impact & Reports
Bucks-for-Brains funding has supported the creation of hundreds of endowed research positions, drawing top talent to Kentucky to further work that saves and improves lives.
Innovation with Impact
Since its inception, the Bucks-for-Brains program has been invaluable in supporting the University of Louisville's efforts to recruit and retain exceptional talent and, in turn, accelerate economic development. With the $10 million in new funding allocated this year, combined with private donations, we hope to expand this effort, drawing even more world-class faculty to UofL and to Kentucky.
These new endowed faculty positions will help us to advance groundbreaking research in cybersecurity, energy, health and more, building on past investments that have supported the creation of more than 160 endowed chair, professor and fellow positions with a focus on groundbreaking and impactful research.


BY THE NUMBERS
In R&D expenditures attributable to Bucks-for-Brains in FY22. Since authorized in 1997, UofL’s federally funded R&D expenditures have skyrocketed.
Number of graduate students who received support from endowment proceeds in FY22.
Total contribution to the state’s economy in FY22, considering awards of external research grants and contracts. This investment is a seed that grows.
Employment impact of the Bucks-for-Brains program in FY22, including endowed positions, research staff, post-docs, etc.
Improving the Lives of Kentuckians
These researchers’ important work, supported by the Bucks-for-Brains program, improves our world in a very real way. Their work creates new products, companies, a trained workforce and jobs. Their work shows that the university, and its home state, take a leadership role in bringing those big ideas to life. Never has that impact been more evident than during the COVID-19 pandemic, when UofL researchers and innovators worked to combat health, societal and economic impacts here and around the world.
Over the past two fiscal years, UofL’s Bucks-for-Brains endowed researchers developed COVID-19 fighting nasal sprays, worked to support minority-owned manufacturers and improve equity for STEM faculty. In the 2022 fiscal year alone, these researchers’ work created 551 jobs and contributed $133.2 million to the Kentucky economy.
These are just a few ways our Bucks-for-Brains researchers continue to grow our Commonwealth and solve the important problems worth solving - ones that save and improve lives. This new investment is a positive step toward accelerating that growth and creating thriving futures for us all.
Stories